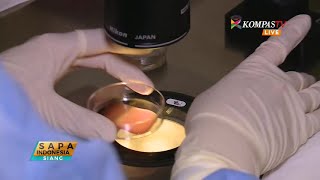

- Fertilisasi dan Perkembangan Embrio

Contoh Pelajaran Biologi Kelas 9 Bab 2, tentang Fertilisasi dan Perkembangan Embrio. Watch Now
Watch Now
- MENAKJUBKAN! Beginilah Proses Pembuahan Terjadi

Video animasi ini menjelaskan proses pembuahan manusia sesaat setelah ejakulasi hingga membentuk janin yang siap untuk tumbuh dan berkembang. Watch Now
Watch Now
- PROSES TERJADINYA BAYI KEMBAR #Woman.Net

PROSES TERJADINYA BAYI KEMBAR SUBSCRIBE: https://www.youtube.com/channel/UCYL_BHy8R06m_xoor80_HCQ?sub_confirmation=1#_=_ Kembar ... Watch Now
Watch Now
- 5 HEWAN MINTA TOLONG PADA MANUSIA

5 hewan minta tolong pada manusia , bagaimana menurut kalian dengan hewan ini..? ------------------------------------------------------------ Daftar terkini mengajikan ... Watch Now
Watch Now
- Cara Msknya Sprm kdlam Rahim stelah brhngn 1ntm

Cara Msknya Sprm kdlam Rahim stelah brhngn ntm http://desainkecantikan.blogspot.com Setelah sel telur dilepaskan, sel telur akan melewati tuba falopi ... Watch Now
Watch Now
- SubhanALLAH..,proses terbentuknya janin

Setelah proses pembuahan, materi genetik dalam sperma dan sel telur yang telah dibuahi atau zigot berkombinasi membentuk sel-sel baru. Sel-sel yang ... Watch Now
Watch Now
- Kelas 9 - IPA - Sistem Reproduksi pada Manusia

Mengapa pada pembentukan sel kelamin melalui proses pembelahan meiosis?Coba perhatikan dan pahami keterangan organ-organ penyusun sistem ... Watch Now
Watch Now
- 113654019 Fertilisasi dan Perkembangan Embrio Manusia

Dalam video ini di bahas tentang fertilisasi dan perkembangan embrio manusia yang menunjukkan kebesaran Sang Maha Kholik atas segala ciptaanNya yaitu ... Watch Now
Watch Now
- pembuahan sel telur oleh sperma

 Watch Now
Watch Now
- Aneka Bentuk Janin Hewan Dalam Rahim Induknya

Karunia Tuhan yang luar biasa. Watch Now
Watch Now
- Yuk, Mengenal Program Bayi Tabung
Kehadiran buah hati menjadi dambaan bagi sepasang suami istri. Namun, bagi sejumlah pasangan yang belum dikarunia anak, program bayi tabung atau in ... Watch Now
Watch Now
- Pembentukan sperma dan ovum

 Watch Now
Watch Now
- IPA SMP kelas 9: Proses dan Siklus Menstruasi

 Watch Now
Watch Now
- HOT-Process pembuahan janin

Terjadinya janin antara sperma dan indung telur Ini adalah contoh terjadinya janin dalam rahim. Jutaan bahkan milyaran saingan kita pada saat itu. Watch Now
Watch Now
- Ovulation | Artificial Insemination | Timing : A Golden Retriever Story (2018)

Ovulation | Artificial Insemination | Timing : A Golden Retriever Story (2018) While breeding dogs might sounds easy, uncommon situations might arise. In order ... Watch Now
Watch Now
Rabu, 25 September 2019
Peristiwa Yang Terjadi Selama Fertilisasi Pada Hewan Adalah
Langganan:
Posting Komentar (Atom)
Tidak ada komentar:
Posting Komentar